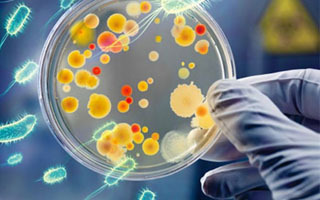

La resistencia a los antimicrobianos es el fenómeno por el cual un microorganismo deja de ser afectado por un antimicrobiano al que anteriormente era sensible. Si está buscando información sobre la resistencia antimicrobiana, o le interesa el tema, le invitamos a que visite la sección de Referencias Bibliográficas y echarle un vistazo a nuestro nuevo producto sobre el tema.
Puede también desgargarlo directamente aquí.
Enviar un comentario nuevo